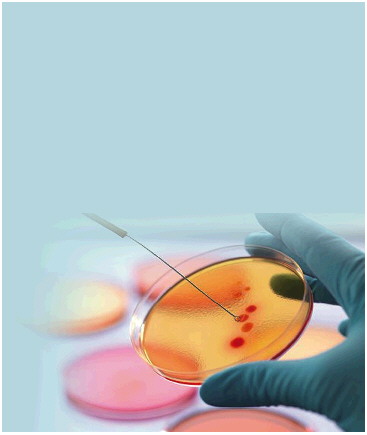

当孩子被确诊为白血病、重型再生障碍性贫血等严重疾病时,很多家庭会陷入绝望。而造血干细胞移植,作为治疗这类疾病的重要手段,常常被视为“生命的转机”。
但是,对大多数家长来说,这一医疗技术充满未知——什么是造血干细胞?所有白血病都需要移植吗?移植成功率如何?日前,山东第一医科大学第一附属医院(山东省千佛山医院)儿科主任兼儿童血液内科主任王红美做客《壹点问医》,就这些问题进行了详细解答。
记者 秦聪聪 济南报道
从“生命种子”
到救命手段
要理解造血干细胞移植,首先得认识造血干细胞本身。
王红美介绍,造血干细胞就像血液系统里的“种子”,能分化成血液里的三大类关键细胞:红细胞负责运输氧气,让身体各器官获得能量;白细胞是“免疫卫士”,抵抗细菌、病毒等外来入侵者;血小板则是“止血小能手”,防止受伤后出血不止。
正是这些细胞的协同工作,维持着人体正常的生理功能,而造血干细胞就是生产它们的“源头”,持续为血液系统和免疫系统提供新鲜力量。
也是因为造血干细胞的特殊作用,目前造血干细胞移植已经成为治疗多种严重儿童血液疾病的重要手段。不过,并非所有血液疾病都需要造血干细胞移植。
王红美介绍,白血病是否需要移植,要先进行“危险度分层”。 医生会根据孩子的白血病类型、基因特点、早期治疗反应等,把病情分为低、中、高危三个等级。
像急性淋巴细胞白血病,大部分标危、中危患儿通过规范化疗,就能获得很高的治愈率,无需移植;只有高危且伴有特定不良基因(如费城染色体阳性)、化疗效果差或复发的患儿,才建议移植。
而急性髓系白血病复发风险相对更高,大部分中高危患儿在第一次病情缓解后,就需要通过移植实现根治。
除了白血病这类血液肿瘤,造血干细胞移植还能治疗其他多种疾病——这些病虽非癌症,却同样致命。比如重型再生障碍性贫血、先天性免疫缺陷病、粘多糖贮积症、脑白质营养不良等遗传代谢性疾病。
多数患儿移植后
能长期生存
近年来,随着技术成熟,造血干细胞的移植成功率也在增加,绝大多数孩子都能够通过移植获得长期无病生存。
王红美介绍,影响成功率的关键因素主要有三个,首先是患者自身状况,包括原发病是什么、移植时病情是否得到很好控制,以及孩子重要脏器功能是否完好。
第二是供者选择与配型情况。一般来说,年轻男性供者是最佳选择,但到底是全合好还是半合好,是脐带血好还是外周干细胞好,具体到每种疾病,选择重点不一样。
最后是移植中心的经验,一个经验丰富的中心,在并发症的预防和处理上会更有优势,能为移植成功保驾护航。
从配型到移植完成,整个流程大概需要1-2个月。
首先是寻找供者,若用亲属供者,几天就能出配型结果;若找无关供者,可能需要一个月。
接着是移植前评估,供者和患儿都要做详细体检,约3-5天。 然后孩子会住进无菌层流病房,进行一周左右的预处理——通过大剂量放化疗,清除体内病变细胞,为新干细胞“腾地方”。
之后就是核心的干细胞输注,像输血一样,把采集好的干细胞输给孩子,1-2小时甚至十几分钟就能完成。最后是2-3周的植活期,在仓内等待新干细胞生根发芽,长出新的血细胞。
面对这项技术,有些家长会因为担忧而犹豫。王红美提醒,移植决策的核心在于“获益与风险的权衡”。当疾病本身通过保守手段无法治愈,而移植能够带来根治或显著改善生活质量的希望时,且移植相关风险可控,那么移植便是一个值得选择的方向。
移植成功后
这些注意事项要牢记
王红美指出,移植过程中,孩子可能面临一些风险和并发症,比如预处理药物的毒性反应、细菌或病毒感染、移植物抗宿主病、出血性膀胱炎等。
不过这些风险并非无法应对,医院会采取一系列措施保障孩子安全:孩子会住在百级层流洁净病房,吃无菌饮食,每天进行体表和五官消毒;医生会预防性使用抗真菌、抗病毒药物,24小时密切监测孩子的生命体征和脏器功能,一旦发现问题苗头,就能及时处理。
移植成功后,帮孩子回归正常生活,是家长和医生的共同目标。出院后半年内,孩子的免疫系统还没完全恢复,建议居家休养,避免去人多拥挤的地方,不接触活疫苗或接种活疫苗的孩子,同时注意饮食卫生。通常在移植后半年到一年,医生会评估孩子的免疫功能,若恢复良好,就能考虑重返校园。
日常活动方面,适度锻炼能增强体质,家长可以鼓励孩子每天运动,上学后也能参与体育活动。心理上,要帮孩子建立自信,鼓励他们和同龄人交流,移植期间也可以继续学习;家长要以平常心对待,避免过度保护,让孩子像其他同龄人一样做手工、玩游戏、写作业。
“千万不要因为孩子看起来好就擅自停药或中断复查,这很危险。”王红美强调,坚持长期规范随访,是保证移植最终成功的“最后一道防线”。移植后1-2年甚至更长时间,孩子都处于恢复阶段,定期随访,能让医生监测免疫功能、调整免疫抑制剂用量、关注生长发育和性腺发育,还能筛查远期并发症。
“请相信孩子的生命力,相信现代医学,也相信我们医疗团队——我们会用全部的知识和爱心,陪你们和孩子一起闯过难关。”王红美表示。